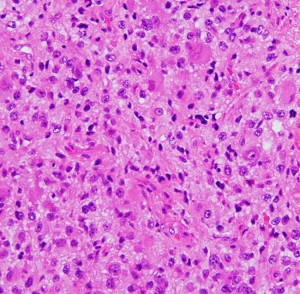

神経節細胞腫,神経節膠腫
神経節細胞腫 gangliocytoma グレード 1
神経節膠腫 ganglioglioma グレード 1, 3
- 80%が30歳以下で,子供から若い成人にできるめずらしい腫瘍です
- 多くは良性で,子供のときにけいれん(症候性てんかん)で発症するのが一般的です
- 脳や脳幹部や脊髄のどこにもできる腫瘍ですが,側頭葉に多いです
- 側頭葉てんかんの原因として最も多い腫瘍です
- この腫瘍は正確な病理診断が難しいものです
- 神経節細胞腫の方がまれですがグレード1なので摘出すれば治ります,あるいは何もしなくても大きくならないことがあります
- 問題は,神経節膠腫で,これにはグレード1と3が知られています
- グレード1の神経節膠腫のほうが多いですが,この良性の神経節膠腫は手術摘出で治ります
- とても良性のものはのう胞(水たまり)や石灰化があって,丸い塊のようにみえるのが特徴です
- 治療法はいずれのグレードでも手術で可能であれば全部取ることがお勧めです,でもグレード1のものは取り残しても問題ありません
- 手術で腫瘍をとるとてんかん発作も収まることが多いです
- グレード1で問題となるものは,大脳基底核や脳幹部に発生するものです,手術摘出できませんし,放射線治療も化学療法も有効ではないので困ります
- とてもめずらしいものですがグレード3の神経節膠腫の生命予後はとても悪く,治療法にも確実なものはありませんし,退形成性星細胞腫や膠芽腫に似た経過をたどります
- 悪性のものは,他の神経膠腫と区別がつかないような画像に見えます
- 手術で取りきれないグレード3 退形成性神経節膠腫には54グレイくらいの放射線治療が勧められますが,それでも再発することもあります
- 制がん剤で有効なものは知られていません
- 半数くらいで,BRAF V600E alteration が認められます
- BRAF阻害剤などが期待されています
病理像が近似している小児腫瘍があります,乳児の大脳の巨大なもの (線維形成性乳児神経節膠腫,desmoplastic infantile ganglioglioma) や,小脳から脳幹部にできる大きなもの (レルミット・ダクロス病,Lhermitte-Duclos disease) や,下垂体から視床下部にできる神経節膠腫 (intrasellar ganglioiglioma) は別な疾患として扱われます
gangliogliomaのWHO分類 (2016年)の変更点
ganglioglioma (grade 1) 神経節膠腫グレード1
anaplastic ganglioglioma (grade 3) 退形成性神経節膠腫グレード3
- 2016年の分類では,grade 2がなくなりました
- 2021年の分類ではanaplasticという接頭語が省かれて,たんにganglioglioma grade 3とされます
- グレード1は,良性で手術で摘出すれば治ります
- グレード3は,放射線化学療法も効かない高度の悪性腫瘍です
- 分裂像,微小血管増殖,壊死,MIB-1 >5%, 細胞核多型性などあればgrade 3となります。

大小の神経細胞とグリア細胞が混在して存在します
小型のグリア細胞にも多少の異型があり腫瘍性グリアと考えられます
グレード1のgangliogliomaです
画像上の特徴
- 半数くらいは側頭葉の限局生病変です
- 星細胞系腫瘍とは異なり皮質が病変の中心となります
- 前頭葉と側頭葉にまたがる病変はほとんどありません single cerebral lobe
- 腫瘍境界は比較的明瞭で,広範囲のびまん性白質浸潤像をしめしません
- しばしばのう胞や石灰化を伴います
- 増大しないか,年余の経過では少し大きくなることもあります
- 側頭葉とは限らず,もちろん脳脊髄のどこの場所にも発生するものです
特に,側頭葉にできて,てんかんで発症するものは長期予後がよい良性例です
治療
- 開頭手術で摘出します
- 摘出できないかつ増大傾向のあるものには放射線治療をしますが,有効性は低いです
- 化学療法の有効性は知られていません
- 手術で大切なことは,初回手術で「てんかんの外科手術」をしないことです,腫瘍だけを摘出するとてんかん発作が止まることが多いからです
- 腫瘍を摘出しても,薬で発作のコントロールが難しいものには,てんかんを止めるための手術を検討します
- 従来の治療に抵抗性のものには,BRAF阻害剤のタフィンラー(ダブラフェニブ)とメキニスト(トラメチニブ)の併用投与が保険診療でできます
- BRAF v600遺伝子に変異のある例で,タフィンラーカプセル(ダブラフェニブ,BRAF阻害剤),メキニスト錠(トラメチニブ,MEK阻害剤)を経口投与するものです
画像と病理
小児の神経節細胞腫 gangliocytoma グレード1(過誤腫のような良性腫瘍)
10才の時に,複雑部分発作(症候性てんかん)で発症しました。吐き気を感じた後に嘔吐して意識が遠くなる(意識減損)という症状であり,側頭葉てんかんです。脳波では左側頭葉に徐波律動がみられました。発作は頻回でしたがカルバマゼピンの投与で抑制されていましたが,MRIで腫瘍が発見されました。
左内側側頭葉グリオーマ mesial temporal glioma と呼ばれる腫瘍です。左の扁桃体,海馬鉤,海馬,海馬傍回に腫瘍が浸潤しています。T2強調画像とFLAIRでまだらな高信号で境界ははっきりしません。mass effectが少なく,増殖増大傾向のある腫瘍には見えないのが特徴です。下段右のように部分的にガドリニウム増強されるのも神経節細胞腫の特徴かもしれません。しかし,神経節膠腫,乏突起膠腫,乏突起星細胞腫(グレード2)なども疑われます。
手術中の脳波モニターでは,棘波が上側頭回の後方(ウェルニッケ領域)に存在し,深部電極刺入で海馬近傍にも棘波がみられましたが,もちろん上側頭回や海馬の切除はしませんでした。扁桃体 amygdala と海馬鈎 uncus の腫瘍部分のみを切除して手術を終了しています。海馬と海馬傍回には腫瘍を残しました。上のMRIは,その後6年経過した後のものですが腫瘍は全く同じ大きさです。抗てんかん薬も止めて,発作は全く生じていません。このような腫瘍は,扁桃体と海馬鉤を摘出することで,発作を完全に止めることができることがあります。ですから,最初の手術では,リスクのある余分な脳切除をしません。
大脳皮質に大型の核を有する円形の神経細胞が散在しています。神経細胞間にグリア細胞がありますが腫瘍性増殖を示しません。MIB-1は1%以下でした。血管周囲にリンパ球浸潤があります。
小児の良性の神経節膠腫 ganglioglioma グレード1(真の腫瘍)
7才の時に音読でつかえるようになり,眼で何かを追っているような欠伸発作(左側頭葉てんかん)を繰り返すようになり,強直間代発作を生じて腫瘍が発見されました。下側頭回底面の皮質に発生した境界明瞭な腫瘍であり,周囲に脳浮腫を伴っています。T2強調画像で線維成分の多い硬い部分は低信号に,軟らかい部分はやや高信号となり,ガドリニウムでheterogenousに増強されます。グレード1の神経節膠腫としては非典型的な画像所見で術前診断は難しいもので,PXA pleomorphic xanthoastrocytoma も疑いました。もちろん治療としては開頭手術での全摘出です。術後に発作は消失しています。
構成要素はGFAP陽性の膠細胞が多く認められます。神経細胞様形態の細胞 ganglion cellではNeuN(+), CGA (+) synaptophisin (++), neurofilament (+)です。大型で腫大した核を有して核内封入体構造を有する好酸性もしくは淡明な細胞質を有する細胞が増殖してPXAを考えさせる部分像もありました。granular bodyも認められて,右の写真のように膠原線維の増生が目立つ部分もあります。これは表面の非常に硬い線維性の腫瘍部分です。MIB-1 indexは4%とやや高い値です。BRAF v600Eの変異が認められました。
神経節細胞腫は放射線治療抵抗性
Tourette syndrome(音声と行動のチック,不随意運動)で発症した男児です。石灰化もありのう胞も伴う大脳基底核gangliocytoma grade 1で,摘出にはリスクがあると判断して46グレイ23分割の定位放射線治療をしました。しかし治療抵抗性で増大したために,上側頭溝からの経路で腫瘍を摘出(右の画像)しました。それ以来13年が経ちますが再発はありません。グレード1の神経節細胞腫は放射線治療抵抗性のものが多いと考えた方がいいし,より大きな線量を使用しても同じ結果なのでしょう。
脳幹部から発生した退形成性神経節膠腫 grade 3
軽い右顔面神経麻痺で発症した小児で,右上下肢の軽度の失調症もありました。脳幹部(橋)の右背側から発生した腫瘍で,軽度の閉塞性水頭症を合併しています。左はT2強調画像で,橋の右側ににじむような浸潤像と浮腫があります。腫瘍は小嚢胞を形成してT2強調画像で実質は等信号です。真ん中の画像はCISS画像で橋が腫大しているのがよくわかります。右側はガドリニウム増強像で,全体が増強されてまだらな増強所見となっています。正中後頭下開頭で全摘出 gross total removal して,局所放射線治療とtemozolomide, cisplatine, etoposide, gleevec, hydoreaなどの化学療法を行いましたが,手術後4ヶ月で激しい播種再発を来しました。
軟膜下伸展とV600Eの変異がある例

てんかん発作が難治化したために全摘出をしてから,3年後に生じた再発のMRI画像です。もともと左下側頭回底部にあって境界明瞭で完全摘出できたと考えていましたが,硬膜に癒着するような小さな脳表面再発が生じました。画像で見える再発像の周囲の軟膜が硬く,周囲表面の脳皮質を含めて,supratotal resectionしました。それ以降,再発はありません。


左は腫瘍の軟膜下の這うような浸潤伸展像です。遺伝子検査では,BRAF V600E遺伝子変異が認められました。
分子診断
- 40%くらいにBRAF v600 mutationがみられます
- 日本では,下記の治験が開始されました
- BRAF v600変異がある腫瘍を有する15歳以下の小児にダブラフェニブ・トラメチニブ投与します
- 杉山未奈子先生が治験担当者です。
RAF V600変異陽性局所進行・転移性小児固形腫瘍に対するダブラフェニブ・トラメチニブの第II相試験 (jRCTs011220017)
(クリックすると開きます)
文献情報
BRAF V600 mutationのある低悪性度グリオーマには,ダブラフェニブとトラメチニブとの併用が有効
Dabrafenib plus Trametinib in Pediatric Glioma with BRAF V600 Mutations. N Engl J Med 2023
下記の学会発表が論文となりました。ダブラフェニブは単独あるいはトラメチニブとの併用で,BRAF V600 mutationを有する低悪性度グリオーマに有効なことが知られています。ダブラフェニブ/トラメチニブとCBDCA/VCRの効果が比較されました。CBDCA/VCRは旧来小児のグリオーマに最も使用された併用化学療法です。ダブラフェニブ/トラメチニブで44%,CBDCA/VCRで11%の奏功率 (CR or PR)が得られました。臨床的な利点はそれぞれ86%と46%でした。PFS中央値は20ヶ月と7.4ヶ月でした。
「一言」PFSが20ヶ月ということは,2年を待たずに再燃するということです。
BRAF V600 mutationのある高悪性度グリオーマには,ダブラフェニブとトラメチニブとの併用がある程度有効
Phase II Trial of Dabrafenib Plus Trametinib in Relapsed/Refractory BRAF V600-Mutant Pediatric High-Grade Glioma. J Clin Oncol 2023
BRAF V600 mutationは小児悪性神経膠腫の8-10%に認められます。41例の再発あるいは治療抵抗性の悪性グリオーマが対象です。奏功割合は56%,反応期間中央値は22ヶ月でした。半分くらいの例で2年弱有効であるという結果です。
BRAF v600変異のあるグリオーマとその比率
Andrews LJ: Prevalence of BRAFV600 in glioma and use of BRAF Inhibitors in patients with BRAFV600 mutation-positive glioma: systematic review. Neuro Oncol 2022
1. epithelioid glioblastoma (eGBM) : 69%
2. pleomorphic xanthoastrocytoma (PXA) : 56%
3. anaplastic pleomorphic xanthoastrocytoma (aPXA) : 38%
4. ganglioglioma (GG) : 40%
5. anaplastic ganglioglioma (aGG) : 46%
6. Prevalence in astroblastoma : 24%
7. desmoplastic infantile astrocytoma (DIA) : 16%
9. subependymal giant cell astrocytoma (SEGA) : 8%
10 dysembryoplastic neuroepithelial tumor (DNET): 3%
11 diffuse astrocytoma (DA) : 3%
12 pilocytic astrocytoma (PA) : 3%
文献情報
小児の低悪性度グリオーマに対するBRAF阻害剤には有効性がある,第2相試験
Bouffet E: Primary analysis of a phase II trial of dabrafenib plus trametinib (dab + tram) in BRAF V600–mutant pediatric low-grade glioma (pLGG). J Clin Oncol 2022, ASCO abstract
学会発表された結果です。BRAFv600変異を有する小児低悪性度グリオーマ110例に対する,dab/tram vs CBDCA/VCRの無作為第2相試験です。ダブラフェニブ twice daily (<12 y, 5.25 mg/kg/d; ≥12 y, 4.5 mg/kg/d) とトラメチニブ once daily (<6 y, 0.032 mg/kg/d; ≥6 y, 0.025 mg/kg/d) が投与されました。観察期間中央値19ヶ月。奏効割合 (CR, PR) は,dab/tramで47%,CBDCA/VCRで11%でした。dab/tram無増悪生存期間中央値は20ヶ月で,有害事象として発熱が7割くらいにみられました。
BRAF V600遺伝子変異があるものにMARK阻害剤が有効
Berzero G: Sustained tumor control with MAPK inhibition in BRAF V600–mutant adult glial and glioneuronal tumors. Neurology 2021
MARK阻害剤 (RAFi/MEKi)の効果を検証した論文です。再発あるいは播種した,成人の神経節膠腫9例,多型黄色肉芽種9例,びまん性グリオーマ10例にこの治療がなされていました。全ての例が高悪性度腫瘍の画像所見を有していました。vemurafenib, dabrafenib, cobimetinib, trametinib などの薬剤が使用されています。11例39%に明らかな腫瘍縮小(PR, CR) が認められました。FPSは18ヶ月でした。
BRAFとMEK阻害剤が有効だった
Yau WH: Combination of BRAF and MEK inhibition in BRAF V600E mutant low-grade ganglioglioma. J Clin Pharm Ther 2020
グレード1の神経節膠腫に,BRAF (vemurafenib) と MEK (cobimetinib)阻害剤が効果 PRを示したとの症例報告です。
BRAF V600E 遺伝子変異がてんかん発作を引き起こす
Koh HY, et al.: BRAF somatic mutation contributes to intrinsic epileptogenicity in pediatric brain tumors.Nat Med. 2018
神経節膠腫は難治性てんかんを生じやすい腫瘍です。これはBRAF V600Eの遺伝子変異があるためだと報告されました。BRAFが,イオンチャンネルと神経伝達物質受容体を制御するRESTという因子に異常を生じるためです。マウス実験では,BRAF V600E変異遺伝子の働きを抑制するvemurafenibの投与で発作が抑制できたということです。
BRAF陽性の脳幹部神経節膠腫にベムラフェニブ vemurafenibが有効であった
Aguilera D, et al.: Successful Retreatment of a Child with a Refractory Brainstem Ganglioglioma with Vemurafenib. Pediatr Blood Cancer 63:541-543, 2016
神経節膠腫グレード1は化学療法や放射線治療に抵抗性の治療として知られています。しかし,脳幹部の神経節膠腫は摘出することができませんから,部分摘出あるいは生検術後に局所放射線治療がされます。アトランタ・エモリー大学からの報告で,この放射線治療6ヶ月後に増大した神経節膠腫にVemurafenib (660 mg/m(2) /dose)を1日2回投与したところ腫瘍が著しく縮小したということです。でも投与を中断したら3ヶ月後に再増大しました。この神経節膠腫は,BRAF V600Eが陽性でした。ベムラフェニブは,BRAFがV600E変異を有するときにMAPK/ERKシグナル伝達経路上のB-Raf/MEK段階を阻害して,腫瘍細胞をアポトーシスに導くとされています。
側頭葉の典型的なものと,それ以外の非典型的神経節膠腫の違い
Patibandla MR, et al.: Atypical pediatric ganglioglioma is common and associated with a less favorable clinical course. J Neurosurg Pediatr 17:41-48, 2016
コロラド大学からの報告です。小児の神経節膠腫 37人のうち,てんかんで発症して側頭葉に限局する典型的な病変が半数くらい,他の半数は「てんかんのない側頭葉以外の神経節膠腫」として比較されました。典型的なものは全摘出が可能で長期生存が極めて良好でした。この非典型的な神経節膠腫の半数以上 11例は脳幹部のもので,ほとんどが全摘出 GTR できず,追跡期間中央値38ヶ月で31%が死亡したとあります。
「解説』BRAF exon 15の変異率は同じで,この予後の大きな違いは単に腫瘍の発生部位によるものなのでしょう。放射線も化学療法も効きづらいグレード1の腫瘍の特徴とも言えます。いわゆる「出た場所が悪い」と厳しい予後が待っている腫瘍でもあります。
成人の頭頂葉の例

無症状で偶然発見されたものです。CTで石灰化があり,部分的にガドリニウム増強されます。乏突起膠腫グレード2との鑑別が難しい例です。乏突起膠腫より放射線化学療法に治療抵抗性ですから,もちろん治療選択は全摘出です。
multinodular and vacuolating neuronal tumor of the cereberum
成人の側頭葉表面に見られる過誤腫のような腫瘍です。無症候性のものが多く,症候性てんかん(側頭葉てんかん)を生じることもあります。T2/FLAIR画像で高信号,T1で低信号,ガドリニウム増強されず,mass effectを有しません。大脳表在性で結節様腫瘍にみえます。腫瘍というより過誤腫あるいは皮質異形成と捉えたほうがよいでしょう。症状のないものは生検に留めます,てんかん発作を生じるものは腫瘍摘出のみをします。